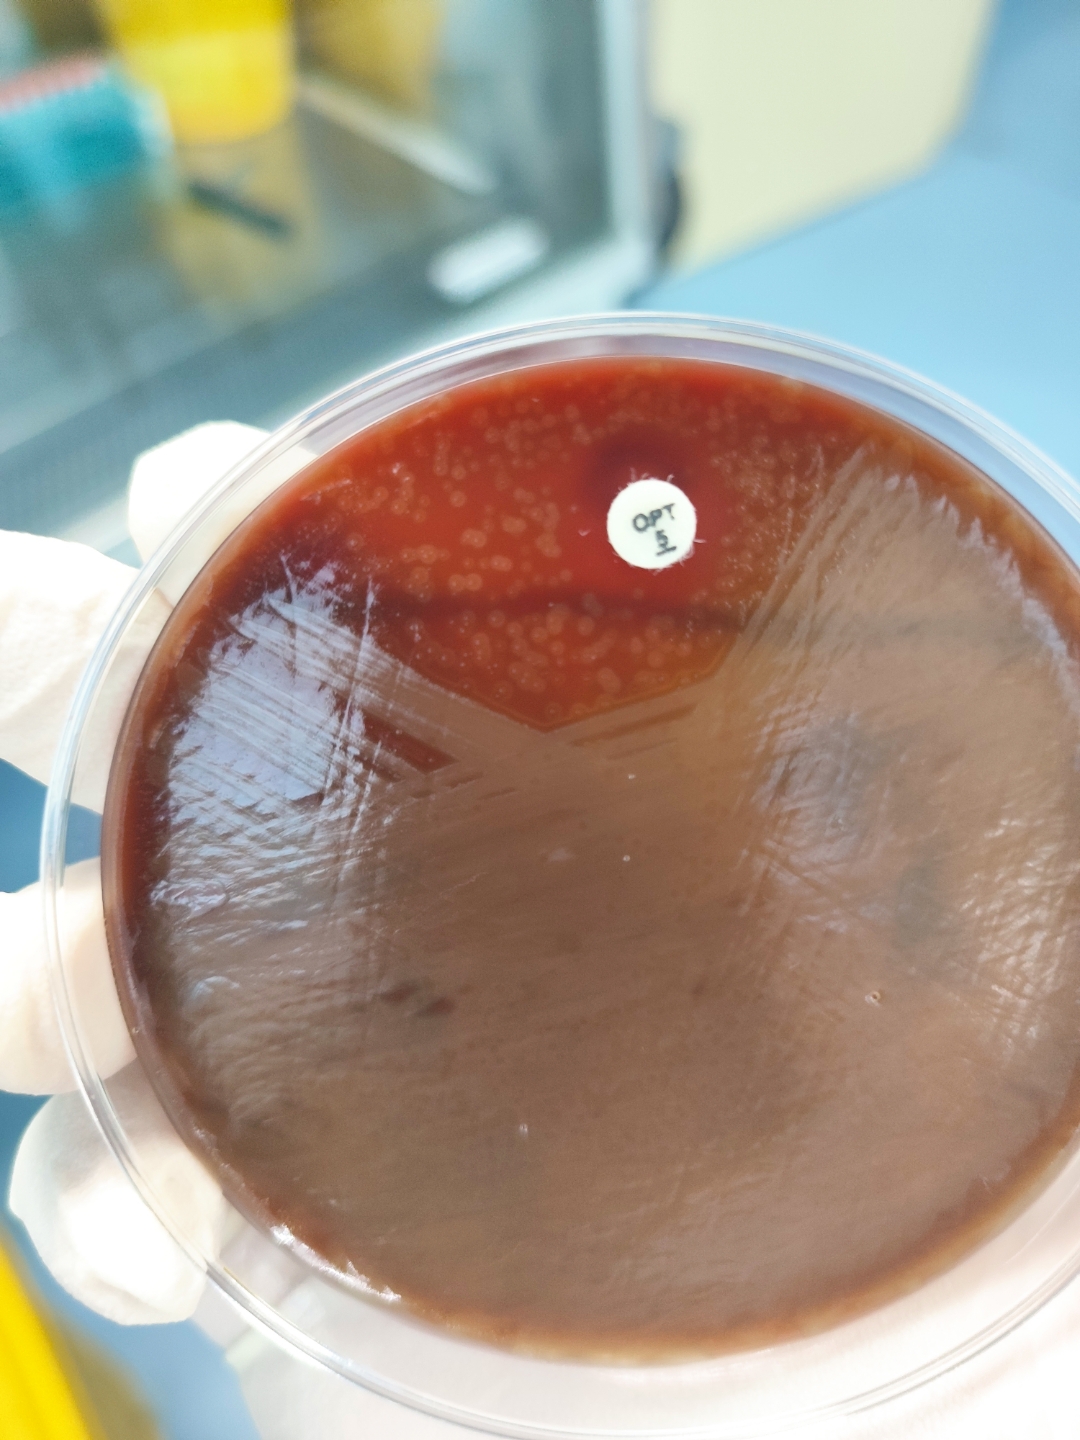
铁锈色痰.肺链.

铁锈色痰图片

铁锈色痰
图片尺寸400x300
痰液颜色,ps:学习笔记,仅供参考.颜色不同,病因不同#护士 - 抖音
图片尺寸1080x1440
一文讲清不同颜色的痰提示什么病菌感染欢迎收藏
图片尺寸1079x1391
早晨起来有痰 吐出来 颜色特别重 第一次吐出来颜色这么重的痰 而且
图片尺寸450x600
铁锈色痰.肺链.
图片尺寸1080x1440
医生说是咽炎,但吃药一直不见好转,最近这几天出现了此图中的痰色!
图片尺寸1024x768
化疗后吐痰深褐色
图片尺寸1000x1000
每天早晨痰都是这样的
图片尺寸450x600
痰是这样的,看起来是一片片的小点点,颜色棕黄色或者更深一点,夏天没
图片尺寸500x375
我的痰为什额是这种颜色
图片尺寸600x800
医生说是咽炎,但吃药一直不见好转,最近这几天出现了此图中的痰色!
图片尺寸768x1024
咳出来的痰是这样的,出什么问题了?
图片尺寸375x500
我的戒烟日记,第9天(咳黑痰)
图片尺寸640x480
吐出来的痰怎么会这样啊?看相片
图片尺寸612x816
医生说是咽炎,但吃药一直不见好转,最近这几天出现了此图中的痰色!
图片尺寸1024x768
铁锈色痰.肺链.
图片尺寸1080x1440
铁锈色痰 - 搜狗百科
图片尺寸250x200
肺部出问题,痰液会给出"通知"?咳出5类痰液,或许应该多留意
图片尺寸640x462
痰…求科普
图片尺寸1536x2048
戒烟后吐出来的黑痰是什么物质
图片尺寸2048x1536